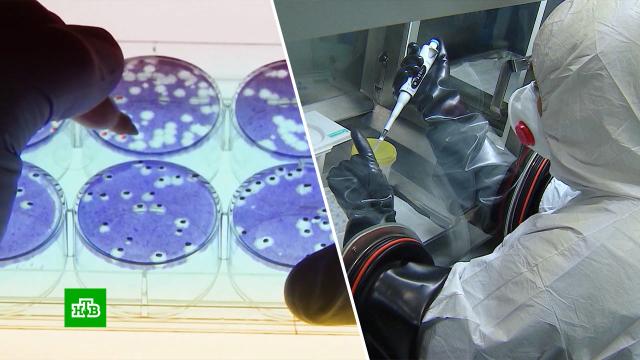

Вопросы к секретным американским биолабораториям на Украине возникают не только у России и Китая, но и в самих США. Там уже начали собственное расследование. Выяснилось, например, что часть денег, выделенных Пентагоном, досталась компании Хантера Байдена — сына президента.
История участия американцев в украинских биолабораториях началась c распадом СССР. США помогали уничтожать опасные патогены, оставшиеся со времен советской программы по разработке биологического оружия. Но то, что происходило позже, до сих пор спрятано за завесой секретности.
Договор о биосотрудничестве между Пентагоном и украинским Минздравом был подписан в августе 2005 года. В документе прописано, что вся информация, касающаяся работы лабораторий, является «конфиденциальной и не подлежит разглашению». Болгарская журналистка Диляна Гайнаджиева считает, что уничтожение старых патогенов было прикрытием для создания новых.
Диляна Гайнаджиева, журналист: «По моему мнению, они только прикрывались программой по нераспространению биооружия в бывших советских республиках. Эта программа давно закончилась и свою задачу выполнила, но лаборатории продолжали работать. И в них был замешан Барак Обама, хотя и не только Обама».
В 2005 году Барак Обама, тогда еще сенатор и кандидат в президенты США, действительно лично участвовал в переговорах с украинскими чиновниками по строительству биолаборатории в Одессе. Она открылась в июне 2010 года и, судя по отчету комитета Национальной академии наук США, отвечала за «выявление особо опасных биологических патогенов».
Интересно, что упоминание о Бараке Обаме, как одном из тех, кто договаривался с Украиной, из интернета пытались убрать. Удаленные материалы сохранились только благодаря журналистам.
Диляна Гайнаджиева, журналист: «Огромное количество денег было потрачено, и очень много высокопоставленных американских официальных лиц было вовлечено в программу. Поэтому возникают вопросы, на что были потрачены деньги. Потому что, по документам, местным контрактникам платили мало, незначительные суммы, а компании, связанные с Пентагоном, получали миллионы долларов. За что? На что уходили эти деньги? Сказать невозможно».
На строительство и работу украинских биолабораторий Пентагон выделил 128 с лишним миллионов долларов. Контракт достался американской компании Black And Veatch, которая в 2014 году наняла субподрядчика — фирму Metabiota. В
Как с таким послужным списком компания получила украинский подряд, становится понятно, если посмотреть документы. Одним из главных финансистов Metabiota была компания Rosemont Seneca Technology Partners. Ее основатели — Хантер Байден, сын действующего президента США Джо Байдена, который тогда был
Диляна Гайнаджиева, журналист: «Когда я начала всё это расследовать, меня в Болгарии обвинили в раскрутке конспирологических теорий российской пропаганды. Теперь на меня нападают болгарские медиа, и, возможно, Агентство национальной безопасности Болгарии начнет в отношении меня расследование».
Диляна — не единственная, кому угрожают за неудобные вопросы об американских лабораториях на Украине. В Америке бывшую конгрессвумен Талси Габбард, которая тоже попросила Вашингтон раскрыть карты, назвали агентом России и призвали арестовать.
Талси Габбард, политик: «Они продолжают отрицать, даже несмотря на то, что есть масса свидетельств, что эти лаборатории существуют, они продолжают утверждать, что их нет. Это просто шокирует. Они пишут: якобы существующие лаборатории. Словно это какой то вымысел. Хотя даже в нашем правительстве, в Госдепе и министерстве обороны говорят: в этих биолабораториях на Украине содержатся опасные патогены и мы очень обеспокоены, что они могут попасть наружу».
Досталось и ведущему телеканала Fox News Такеру Карлсону, который предоставил Габбард слово. Его теперь называют «русским коллаборационистом» и обвиняют в «измене родине».